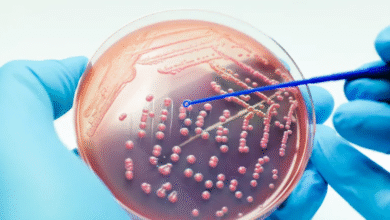

صحة
-

دراسة تكشف آلية خفية وراء عدوانية ورم دماغي نادر يصيب الأطفال
كشفت دراسة علمية حديثة عن اعتماد خلايا الورم الجنيني ذو الزهيرات المتعددة الطبقات (Embryonal Tumor with Multilayered Rosettes)، وهو ورم…
أكمل القراءة » -

اكتشاف علمي غير مسبوق: مؤشر حيوي صغير في الدم قد يُحدث ثورة في تشخيص أمراض الكلى وحمايتها
في إنجاز طبي غير مسبوق على المستوى العالمي، نجح فريق من الباحثين في تحديد جزيء دقيق من الحمض النووي الريبي…
أكمل القراءة » -

علماء روس يبتكرون مادة مضيئة فوق بنفسجية تقضي على 99.9% من البكتيريا خلال 40 دقيقة
نجح فريق من الباحثين الروس في تطوير مادة جديدة ذات قدرة فائقة على إصدار ضوء فوق بنفسجي لمدة قياسية تصل…
أكمل القراءة » -

الولايات المتحدة توقف التوصية بلقاحات كوفيد-19 للحوامل والأطفال الأصحاء بتوجيه من وزير الصحة كينيدي
في إعلان مثير للجدل، كشف وزير الصحة الأميركي روبرت إف. كينيدي الابن، يوم الثلاثاء، أن الولايات المتحدة أوقفت التوصية بإعطاء…
أكمل القراءة » -

الأردن يتصدر الشرق الأوسط في نسب التدخين وسط تحذيرات من أزمة صحية واقتصادية متفاقمة
يواجه الأردن أزمة متصاعدة في معدلات التدخين، جعلته يتبوأ المرتبة الأولى في الشرق الأوسط من حيث نسبة المدخنين بين الأفراد…
أكمل القراءة » -

اضطرابات الغدد الجارات الدرقية: الأسباب، الأعراض، وطرق العلاج
يعاني بعض الأشخاص من اضطرابات في الغدد الجارات الدرقية، مثل فرط النشاط أو القصور، ما يؤدي إلى أعراض صحية متعددة…
أكمل القراءة » -

دراسة أولية: أدوية قديمة للسكري قد تُبطئ انتشار سرطان البروستاتا
كشفت دراسة صغيرة أجراها باحثون في جامعة أوميا السويدية عن إمكانية أن تسهم فئة من الأدوية القديمة المستخدمة لعلاج داء…
أكمل القراءة » -

بلدية نواذيبو تطلق المرحلة 23 من الأيام الصحية بمباني المركز الصحي البلدي “الرضوان”
أطلقت بلدية نواذيبو، صباح اليوم ، المرحلة الثالثة والعشرين من الأيام الصحية، بمباني المركز الصحي البلدي “الرضوان”، بالتعاون مع المنظمة…
أكمل القراءة » -

دراسة حديثة تربط بين انقطاع الطمث وظهور الأكزيما أو تفاقمها لدى النساء
كشف استطلاع جديد وجود علاقة بين انقطاع الطمث وتفاقم أعراض الأكزيما الجلدية، أو حتى ظهورها لأول مرة لدى بعض النساء…
أكمل القراءة » -

باحثون: نهج جديد يعيد الناموسيات إلى الواجهة في مكافحة الملاريا عبر استهداف الطفيلي بدلاً من البعوض
كشف باحثون في دورية “نيتشر” العلمية عن إمكانية إعادة الناموسيات إلى الواجهة كأداة فعالة في مكافحة الملاريا، ولكن هذه المرة…
أكمل القراءة »